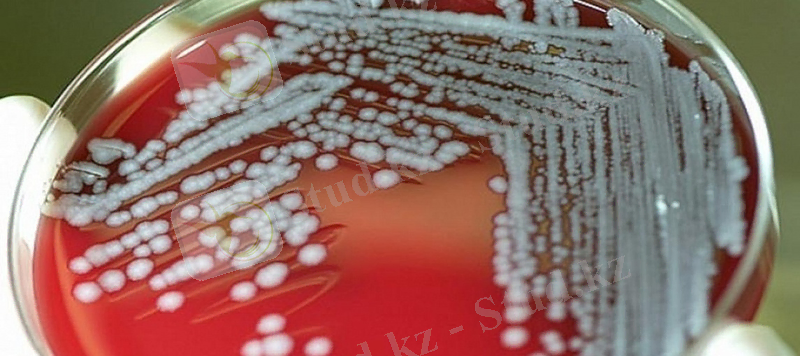
og_og_1576694671272638546.jpg

Індетті аурулар: зооантропоноздар, жануарларды оқшаулау, лабораториялық зерттеу, дезинфекция және өлекселерді утилизациялау


Жәңгір хан атындағы Батыс Қазақстан аграрлық техникалық университеті
Ветеринарлық медицина және мал шаруашылығы институты
Тақырыбы: Індетті аурулар
- Жануарлар мен адамдар арасында бірдей кездесетін қандай індетті ауруларды (зооантропоноздар) білесіз?
- Індетті ауруға шалдыққан жануарларды оқшаулау (изоляция) .
- Індетті аурулар кезінде лабораториялық зерттеуге материалдар алу тәсілі.
- Жануарлар өліксесін утилизациялау.
- Дезинфекция
Аса қауіпті инфекциялар
Аса қауіпті инфекцияларға -оба, туляремия, сібір жарасы, туляремия, сап, тырысқақ жатқызылады. Оба, туляремия, сібір жарасы, туляремия, сап - зооантропоноздар.
Аса қауіпті инфекциялардың үш белгісі бар :
1) Өте жұқпалы.
2) Эпидемия және пандемия шақырады.
3) Ауыр инфекциялар туғызады.
4) Өлімге ұшыратады.
Зооноздар
(зооантропоноздар) деп аталуы олардың инфекция көзі
жануарлар болады:үй жануарлары және жабайы жануарлар. Адамға әр түрлі жолдармен жұғады:зақымдалған тағамды пайдаланғанда, жануарлардың жем суын беріп күткенде, жануарларды сойғанда, етін бөлшектегенде, еттен және сүт өнімдерінен тағамдар даярлағанда жұғуы мүмкін. Зооноздарға жатады:оба, туляремия, сібір жарасы, бруцеллез (сарып) . Осы инфекциялар аса қауіпті инфекцияларға жатқызылады.
Жұғу жолдары:
1. Алиментарлы -Жануарлар өнімдері
2. Ауа-тамшы -шаң-тозаң арқылы
3. Контактілі (қарымқатынас) жарақат арқылы, қан сорғыш
буын аяқты насекомдар
арқылы
4. Трансмиссивті-(кенелер, масалар, бүргелер)

БРУЦЕЛЛЕЗ
Тұқымдасы: Brucellaceae
Түрлері: Brucella melitensis
Brucella abortus
Brucella suis
Қоздырғышты Д. Брюс деген ғалым ашты. 1886 жылы . ( Brucella melitensis) Барлық топқа Brucella деген атау берілді.
Ұсақ таяқша, кейде коккобактериялар. Жағындыда ретсіз орналасқан.
Спорасы, талшықтары жоқ. Нәзік капсуласы болады . Граммен теріс боялады.

Бруцелланың дақылдық қасиеті
1. Аэробтар немесе микроаэрофильдер.
2. Бауыр қосылған ортада жақсы өседі, қан, сары су, глюкоза қосылған
орталарда, тауық жұмыртқасының сары уызында жақсы өседі.
3. Сорпада лайлану, гомогенді тұнба, тығыз ортада-ұсақ колониялар, сұр- ақ
түсті, шағылысқан сәуледе жарқыраған, және кейде мөлдір болады
Бруцеллалның биохимиялық және антигендік қасиеті
Глутаминді қышқылды ферментациялайды, орнитин, лизин және басқа амин қышқылдарын, көмірсуларды ферментациялайды: арабинозаны, галактозаны, рибозаны ферментациялайды. Күкіртсутек түзеді.
Бруцелланың антигендері: А, М - соматикалық антигендер, Brusella
melitensis түрінде М-антигені басымдылық көрсетсе Brusella abortus және Br. suis түрінде Аантиген басымдылық көрсетеді.
Бруцеллалардың патогенді факторы
1. Эндотоксиндер
2. Фагоцитозды басатын факторлар. (табиғаты толық зерттелмеген)
3. Агрессия ферменттері: гиалуронидаза және басқа.
4. Пенетрация факторлары, сол арқылы жүйенің жасушаларына енуі .
5. Жоғары аллергендер (бруцелланың антигендері), баяу жүретін жоғарғы сезімталдылық реакциясын тудырады. Қан және лимфаға түсіп бактеремия
тудырады. Бруцеллалар қанда көбеймейді.
Бруцелланың патогенезі
Біріншілік локализациясы
: Қоздырғыш лимфа түйіндеріне енеді
(ауыз қуысының, ішектің лимфатикалық аппараты), Оларда көбейеді
Қанға немесе лимфаға түседі (бактериемия) лимфо-гемопоэтикалық жүйе тіндеріне-сүйек кемігіне, көк бауырға, паренхиматозды мүшелерге - бауырға
барады. Бауыр, көк бауыр, лимфа түйінінде гранулема түзеді. Бруцелла бұзылғанда эндотоксин босайды.
Екіншілік локализациясы
:
Нерв жүйесі, зәр шығару-жыныс жүйесі, тірек-қимыл
жүйесі. Жүкті әйелде түсік болады.
Бруцеллездің патогенезі мен клиникалық ерекшелігі
а) жасуша ішілік орналасу(локализация) .
б) аяқталмаған фагоцитоз,
в) L -форманың қалыптасуы және ұзақ персистенция.
а) клиникалық көрінісі әр түрлі және күрделі.
б) клиникалық көрініс беруі орналасуына байланысты болады және организмде аллергияның дамуы.
в) бруцеллез ұзақ, созылмалы жүретін ауру барысымен сипатталады, аурудың созылмалы түрге айналуы және ұзақ уақыт еңбекке жарамсыздығымен, мүгедектікке ұшырауымен байланысты ауру.
Бруцеллездің резисценттілігі
Топырақ, суда 2-3 ай сақталады
Тағамдарда:
Сүтте- 273 күн
Майда- 142 күн
Ірімшікте-бір жылға дейін
Брынзада- 72 күн
Қышқыл сүтте- 30 күнге дейін
Айранда- 11 күнге дейін
Қыздырғанда:
70 градусқа дейінС. - 10 мин
100 градусқа -бірнеше секунд
Бруцеллездің диагностикалық әдістері
Бруцеллелаларды тура және тура емес ИФР арқылы анықтауға болады.
1. Бактериологиялық: зерттелетін материал: қан, зәр, сүйек кемігі, экссудат
бауыр қосылған ортаға себу. Идентификациялау: морфологиялық,
тинкториальді, культуральді-биохимиялық Антигенді қасиеттері бойынша.
2. Биологиялық: теңіз шошқасын зақымдау
3. Серодиагностика
а) антигендерді анықтау(қаннан) ПГАР, преципитация және т. б.
б) антиденелерді анықтау:Хедльсон реакциясы, Райт(агглютинация реакциясы), ПГАР, ИФА және т. б. .
4. Аллергиялық:бруцеллинмен тері байқауы Бюрне реакциясы
Бруцеллездің алдын алу
Екпе -тірі әлсіретілген вакцина. Рецидивтің алдын алу үшін спецификалық иммуноглобуллин. Емдеу-этиотропты, кең әсер ету
спектірі бар антибиотиктер.

СІБІР ЖАРАСЫ
Морфологиясы
1. Таяқша, 3-5 мкм, шеті шорт кесілген
2. Жағындыда екіден немесе тізбек құрып
орналасады
3. Қозғалмайды
4. Капсуланы адам организінде түзеді
5. Спорасы сопақ, орталық орналасады
6. Граммен оңға боялады
ДАҚЫЛДЫҚ ҚАСИЕТТЕРІ Bacillus anthracis
Ортаға талапшыл емес,
Тығыз орталарда R - формалы колония түзеді
колониясы “арыстанның желкесі”тәрізді, S - формада -вирулентті емес.
Сорпада-мақтаның түйіндісі түрінде тұнба түзеді. Факультативті анаэроб.
Протеолитикалық қасиеттері:
желатинді ұйыған қан сары суын сұйылтады
сүтті алғашында ұйытып және пептонизацИялайды. Сахаролитикалық қасиеттері: глюкозаны, сахарозаны, мальтозаны, левулезаны, трегалозаны,
декстранды ферменттейді.
Патогенді факторлары
1. Капсула фагоцитоздың әсерінен қорғайды
2. Токсиндер комплексі:
а) Ісікті фактор тамырлардың өткізгіштігін артттырады
б) летальді фактор жануарлардың өлімін тудырады
в) протективті антиген антиденелердің түзілуін тудырады
Сібір жарасы ауруының эпидемиологиясы және клиникасы. Сібір жарасының тері формасы
1. Зақымдалу жолы:Қарым-қатынас (жануар
өліктері, зақымдалған
жануардың еті, терісі, жүні
арқылы) .
2. Ену қақпасы :тері, шырышты қабықша (ошағы)
3. Клиникалық көрініс беруі: Сібір жаралық карбункула ( некроз,
серозды сұйықтық, қара жіпше)

Лабораториялық диагностика
1. Бактериоскопия: карбункуладан жағынды, өліктегі матералдан жағынды-таңба, Граммен, Ожешко әдісімен бояу (споралы формалары)
2. Бактериологиялық ЕПА қоздырғыштың таза дақылын бөлу, пенициллин қосылған ортаға себу (“маржан моншақтары”)
3. Биологиялық әдіс: ақ тышқандарды зақымдау немесе теңіз шошқасын
зақымдап. Ағзадан жағынды-таңба дайындау.
4. Серологиялық әдіс-зерттеу затынан(тері, жүн) Асколи реакциясының көмегімен сақиналы преципитация реакциясы
5. Аллергиялық: антраксинмен тері реакциясы
Спецификалық профилактика
- тірі сібір жарасы вакцинасы- иммунитет 1 жыл
- жедел профилактика- сібір жарасына қарсы иммуноглобулин Спецификалық емес профилактика- Дер кезінде анықтау және изоляциялау
және науқасты емдеу, ветеринарлық шаралар жүргізу.
Індетті ауруға шалдыққан жануарларды оқшаулау (изоляция) .
Індетке қарсы шаралар жұқпалы аурулардың шығуына және олардың таралуына жол бермеуге бағытталады. Жұқпалы ауруларды болдырмау үшін дауалау (алдын алу) шаралары іске асырылады, ал ауру шыға қалған күнде оны жою (сауықтыру) шаралары қарастырылады. Сонымен індетке қарсы шаралар дауалау шаралары және сауықтыру шаралы болып екі салаға бөлінеді. Бұлардың қай-қайсысы болмасын бірнеше салаға бағытталған кешеннен тұрады. Бұл күрделі кешенге кіретін шаралар індет бұғауының барлық буындарына қарсы бағытталуы керек, сондықтан да олар инфекция қоздырушысының бастауына, инфекция қоздырушысының берілу тетігіне және ауруға бейім жануарларға қатысты жүргізіледі.
Іңдетке қарсы шаралар жалпы және арнайы болып екі топқа бөлінеді. Жалпы шаралар кез келген жұқпалы ауруға бағытталған ортақ сипатта болады да, оған ұйымдастыру-шаруашылық және ветеринариялық-санитариялық шаралар жатады. Арнайы шаралар нақтылы бір жұқпалы ауруға қарсы бағытталады да, оған сол ауруды балау және жануарларды иммундеу
Ветеринариялық-санитариялық шаралар, мысалы, қораны мал қиынан тазарту, мал шаруашылығының қалдықтарын зарарсыздандыру және арнайы шаралар - малды ауруға тексеру мен иммундеу, барлығы да ұйымдық-шаруашылық мәселелерімен тығыз байланысты. Ауру малды бөліп алып, оқшаулау , күту, ол үшін еңбекақы төлеу, карантин мен шектеу шараларын орындау, мал өнімдерін зарарсыздандыру, т. б. аурудың шығуынан туындайтын мәселелер де шаруашылық және ұйымдастыру тұрғысынан шешімін табуы керек.
Жұқпалы аурулардың алдын алу үшін жаңадан салынатын мал фермаларына орынды дұрыс таңдап алу қажет. Әсіресе топалаң секілді қоздырушысы топырақта ұзақ жылдар бойы сақталатын аурудан ол жердің сау болуы шарт.
Жұқпалы ауру фермаға басқа мал фермаларынан, елді мекендерден келеді. Сондықтан да мал фермаларын әр түрлі объектілерден санитариялық талаптарға сай ара қашықтықты сақтай отырып орналастыру қажет. Жұқпалы аурудың таралуы үшін терісі бағалы аңдарды, үй қояндарын және құс өсіретін шаруашылықтар ерекше қауіпті болып саналады. Өндіріс орындарының ішінде бұл тұрғыдан мал өнімдері мен шикізаттарын өңдейтін кәсіпорындары (тері заводы, ет комбинаты, т. б. ) қауіп тудырады. Сондай-ақ қатынас жолдарынан, әсіресе ірі транспорт жүйелерінен, мал фермасын қашық орналастырған дұрыс.
Санитариялық тұрғыдан мал фермалары мен кешендері жабық кәсіпорындар қатарына жатады. Сондықтан оларды қоршап, ішке қатынау тек қана дезинфекциялық тосқауыл мен ветеринариялық-санитариялық өткелек арқылы ғана іске асырылуы керек. Ферма мен кешеннің күллі территориясы тұтас немесе торлы қорғанмен қоршалынады. Қорғанның биіктігі кемінде 180см болуға тиіс. Қоршаудың сыртынан ені 1м, тереңдігі 1, 5м ор қазылады.
Ферманың ішкі территориясына қатынайтын көлік, егер мал тұрмайтын шаруашылық аймағына баратын болса (мысалы, жем-шөп әкелгенде), дез-тосқауыл арқылы өтеді. Ал мал тұратын таза аймаққа баратын көлік пен адамдар ветсан өткелек арқылы өткізіледі.
Шаруашылыққа шеттен әкелінген мал табынға қосардан бұрын бір ай бойы карантинде бөлектелініп ұсталынады. Карантин кезінде жануарлар ретті түрде клиникалық бақылау мен лабораториялық тексеруден өтеді. Шаруашылықта ұстау үшін жұқпалы аурулардан сау, арасында микроб алып жүрушілері жоқ малдар ғана жіберіледі.
Карантин кезінде жануарларды індет жағдайына сәйкес кейбір жұқпалы ауруларға қарсы егеді. Бордақылау кешендерінде жаңадан әкелінген бұзаулардың карантиндеу мерзімі 15 күнмен шектелінеді.
Жұқпалы аурулардан сау шаруашылықтарда сақтық шаралары ретінде жануарлардың белгілі бір топтарын кейбір ауруларға, негізінен созылмалы жұқпалы ауруларға, тексеріп отырады. Ондай ауруларға сиырда бруцеллез, туберкулез, лептоспироз, қойда бруцеллез, жұқпалы эпидидимит, хламидиялық іш тастау, жылқыда маңқа, инфекциялық анемия, т. б. жатады.
Дауалық шаралардың ішінде сақтық дезинфекциясы мен дератизациясының маңызы зор. Бұл екі шараны қатар жүргізген мезетте алдымен дератизация жүргізіп, кемірушілердің өлекселерін жинап алғаннан кейін дезинфекция жасалынады.
Індетті аурулар кезінде лабораториялық зерттеуге материалдар алу тәсілі.
Індеттанулық, клиникалық және патологоанатомиялық әдістердің көмегімен кейбір жекелеген жұқпалы ауруларға ғана диагноз қою мүмкін. Көбінде бұл зерттеулердің нәтижесінде белгілі бір ауруға күдіктенуге болады. Бұл арнаулы әдістер аурудын өзіне тән қоздырушысын немесе оған қарсы жануар денесіндегі өзгеше иммунологиялық құбылыстарды айқындауға негізделген. Мұндай арнаулы әдістерге микробиологиялық (бактериологиялық, вирусологиялық), серологиялық және аллергиялық зерттеулер жатады.
Бактериологиялық зерттеу . Бактериологиялық балау әдісі жұқпалы ауруларға шалдыққан жануардың денесінен ауру қоздырушы зардапты микробты табуға негізделген. Микробты табу "индикация" оның қай түрге жататындығын айқындау "идентификация" деп аталады. Бактериологиялық зерттеу үш түрлі буыннан тұрады. Олар: микроскоппен көру яғни микроскопия (микроскоптау), бактерияны қоректік ортада өсіріп өсін алу және лабораториялық жануарларға жұқтырып биосынама қою.
... жалғасы- Іс жүргізу
- Автоматтандыру, Техника
- Алғашқы әскери дайындық
- Астрономия
- Ауыл шаруашылығы
- Банк ісі
- Бизнесті бағалау
- Биология
- Бухгалтерлік іс
- Валеология
- Ветеринария
- География
- Геология, Геофизика, Геодезия
- Дін
- Ет, сүт, шарап өнімдері
- Жалпы тарих
- Жер кадастрі, Жылжымайтын мүлік
- Журналистика
- Информатика
- Кеден ісі
- Маркетинг
- Математика, Геометрия
- Медицина
- Мемлекеттік басқару
- Менеджмент
- Мұнай, Газ
- Мұрағат ісі
- Мәдениеттану
- ОБЖ (Основы безопасности жизнедеятельности)
- Педагогика
- Полиграфия
- Психология
- Салық
- Саясаттану
- Сақтандыру
- Сертификаттау, стандарттау
- Социология, Демография
- Спорт
- Статистика
- Тілтану, Филология
- Тарихи тұлғалар
- Тау-кен ісі
- Транспорт
- Туризм
- Физика
- Философия
- Халықаралық қатынастар
- Химия
- Экология, Қоршаған ортаны қорғау
- Экономика
- Экономикалық география
- Электротехника
- Қазақстан тарихы
- Қаржы
- Құрылыс
- Құқық, Криминалистика
- Әдебиет
- Өнер, музыка
- Өнеркәсіп, Өндіріс
Қазақ тілінде жазылған рефераттар, курстық жұмыстар, дипломдық жұмыстар бойынша біздің қор #1 болып табылады.



Ақпарат
Қосымша
Email: info@stud.kz